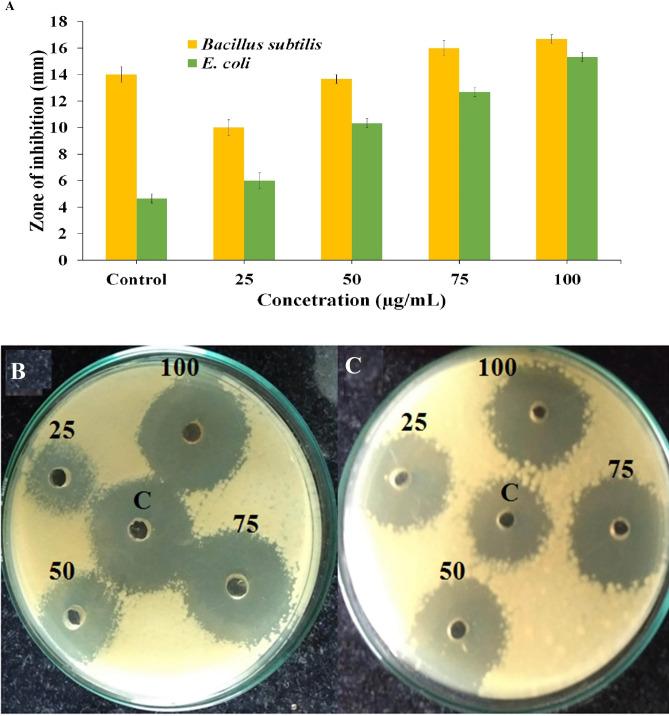
https://cdn.ncbi.nlm.nih.gov/pmc/blobs/7501/7806947/1baa26e90e6b/41598_2020_80327_Fig10_HTML.jpg

从瘤果天门冬提取物中介导的硒纳米粒子的绿色合成及其细胞毒性、抗菌、杀蚊和光催化活性。
Green synthesis of selenium nanoparticles mediated from Ceropegia bulbosa Roxb extract and its cytotoxicity, antimicrobial, mosquitocidal and photocatalytic activities.
机构信息
Ethnopharmacology and Algal Biotechnology Division, Department of Botany, School of Life Sciences, Periyar University, Salem, Tamil Nadu, 636011, India.
Department of Environmental Science, School of Life Sciences, Periyar University, Salem, Tamil Nadu, 636011, India.
出版信息
Sci Rep. 2021 Jan 13;11(1):1032. doi: 10.1038/s41598-020-80327-9.
The present study is to design an eco-friendly mode to rapidly synthesize selenium nanoparticles (SeNPs) through Ceropegia bulbosa tuber's aqueous extracts and confirming SeNPs synthesis by UV-Vis spectroscopy, FT-IR, XRD, FE-SEM-EDS mapping, HR-TEM, DLS and zeta potential analysis. In addition, to assess the anti-cancer efficacy of the SeNPs against the cultured MDA-MB-231, as studies have shown SeNPs biosynthesis downregulates the cancer cells when compared to normal HBL100 cell lines. The study observed the IC value of SeNPs against MDA-MB-231 cells was 34 µg/mL for 48 h. Furthermore, the SeNPs promotes growth inhibitory effects of certain clinical pathogens such as Bacillus subtilis and Escherichia coli. Apart, from this the SeNPs has shown larvicidal activity after 24 h exposure in Aedes albopitus mosquito's larvae with a maximum of 250 g/mL mortality concentration. This is confirmed by the histopathology results taken at the 4th larval stage. The histopathological studies revealed intense deterioration in the hindgut, epithelial cells, mid gut and cortex region of the larvae. Finally, tried to investigate the photocatalytic activity of SeNPs against the toxic dye, methylene blue using halogen lamp and obtained 96% degradation results. Withal computational study SeNPs was shown to exhibit consistent stability towards breast cancer protein BRCA2. Overall, our findings suggest SeNPs as a potent disruptive agent for MDA-MB-231 cells, few pathogens, mosquito larvae and boosts the photocatalytic dye degradation.
本研究旨在设计一种环保模式,通过管叶珊瑚块茎的水提物快速合成硒纳米颗粒(SeNPs),并通过紫外-可见光谱、FT-IR、XRD、FE-SEM-EDS 映射、高分辨率透射电子显微镜(HR-TEM)、动态光散射(DLS)和zeta 电位分析来确认 SeNPs 的合成。此外,评估 SeNPs 对培养的 MDA-MB-231 的抗癌功效,因为研究表明,与正常 HBL100 细胞系相比,SeNPs 的生物合成会下调癌细胞。研究观察到 SeNPs 对 MDA-MB-231 细胞的 IC 值为 34 µg/mL,作用 48 h。此外,SeNPs 促进了某些临床病原体(如枯草芽孢杆菌和大肠杆菌)的生长抑制作用。此外,经过 24 h 暴露后,SeNPs 对 Aedes albopitus 蚊子幼虫表现出杀幼虫活性,最大死亡率浓度为 250 µg/mL。这在第 4 个幼虫阶段的组织病理学结果中得到了证实。组织病理学研究显示,幼虫的后肠、上皮细胞、中肠和皮质区域严重恶化。最后,尝试研究 SeNPs 对有毒染料亚甲基蓝的光催化活性,使用卤灯获得 96%的降解结果。总之,我们的研究结果表明,SeNPs 是 MDA-MB-231 细胞、几种病原体、蚊子幼虫的有效破坏剂,并能增强光催化染料的降解。